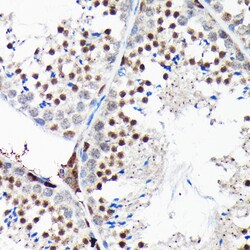
Invitrogen RGS14 Polyclonal Antibody 100 &mu;L; Unconjugated:Antibodies,

Learn More
Invitrogen™ RGS14 Polyclonal Antibody


Rabbit Polyclonal Antibody
Brand: Invitrogen™ PA597309
Description
Immunogen sequence: PPVEGPGGRP LRKSFRRELG GTANAALRRE SQGSLNSSAS LDLGFLAFVS SKSESHRKSL GSTEGESESR PGKYCCVYLP DGTASLALAR PGLTIRDMLA GICEKRGLSL PDIKVYLVGN EQALVLDQDC TVLADQEVRL ENRITFELEL TALERVVRIS AKPTKRLQEA LQPILEKHGL SPLEVVLHRP GEKQPLDLGK LVSSVAAQRL VLDTLPGVKI SKARDKSPCR SQGCPPRTQD KATHPPPASP SSLVKVPSSA TGKRQTCDIE GLVELLNRVQ S; Positive Samples: SH-SY5Y, Mouse kidney; Cellular Location: Cell junction, Cell membrane, Cell projection, Cytoplasm, Membrane, Nucleus, PML body, centrosome, cytoskeleton, dendrite, dendritic spine, microtubule organizing center, postsynaptic cell membrane, postsynaptic density, spindle, spindle pole, synapse.
RGS14 is a member of the regulator of G-protein signaling family which contains one RGS domain, two Raf-like Ras-binding domains (RBDs), and one GoLoco domain. RGS14 attenuates the signaling activity of G-proteins by binding, through its GoLoco domain, to specific types of activated, GTP-bound G alpha subunits. Acting as a GTPase activating protein (GAP), the protein increases the rate of conversion of the GTP to GDP. The resulting hydrolysis allows the G alpha subunits to bind G beta/gamma subunit heterodimers, forming inactive G-protein heterotrimers, thereby terminating the signal. Alternate transcriptional splice variants of RGS14 have been observed but have not been thoroughly characterized. Further, RGS14 acts as a positive modulator of microtubule polymerisation and spindle organization through a G(i)-alpha-dependent mechanism; plays a role in cell division; is required for the nerve growth factor (NGF)-mediated neurite outgrowth, and is involved in stress resistance. RGS14 protein may also be involved in visual memory processing capacity and hippocampal-based learning and memory.
Specifications
| RGS14 | |
| Polyclonal | |
| Unconjugated | |
| Rgs14 | |
| rap1/rap2 interacting protein; RAP1/RAP2-interacting protein; Regulator of G-protein signaling 14; regulator of G-protein signalling 14; RGS14; RGSE; RPIP1 | |
| Rabbit | |
| Affinity Chromatography | |
| RUO | |
| 10636, 114705, 51791 | |
| -20°C, Avoid Freeze/Thaw Cycles | |
| Liquid |
| ELISA, Immunohistochemistry (Paraffin), Western Blot | |
| 0.4 mg/mL | |
| PBS with 50% glycerol and 0.02% sodium azide; pH 7.3 | |
| O08773, O43566, P97492 | |
| Rgs14 | |
| Recombinant fusion protein containing a sequence corresponding to amino acids 230-510 of human RGS14 (NP_0064712). | |
| 100 μL | |
| Primary | |
| Human, Mouse, Rat | |
| Antibody | |
| IgG |
Your input is important to us. Please complete this form to provide feedback related to the content on this product.